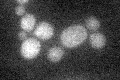
YJL068C
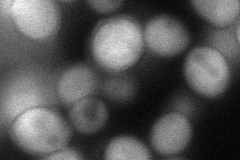
YJL068C
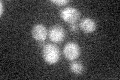
YJL068C
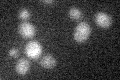
YJL068C

View description
Non-essential intracellular esterase that can function as an S-formylglutathione hydrolase; may be involved in the detoxification of formaldehyde, which can be metabolized to S-formylglutathione; similar to human esterase D
Localization:
Intensity:
Fold change:
Significance:
-
C’ GFP library in SD
below threshold16.37 -
N' NOP1pr-GFP in SD

cytosol226.748 -
N' TEF2pr-mCherry in SD

cytosol396.428 -
N' NATIVEpr-GFP in SD

cytosol35.9924 -
N' TEF2pr-VC and Cyto-VN in SD
cytosol89.1199 -
C’ GFP library in SD+DTT

cytosol17.141.04No -
C’ GFP library in SD+H2O2
cytosol16.140.98No -
C’ GFP library in Starvation Media
cytosol19.21.17No -
C’ GFP library on the background of Pup2-DaMP

below threshold -
C’ GFP library on the background of CCT mutant

below threshold17.78331.08566No
